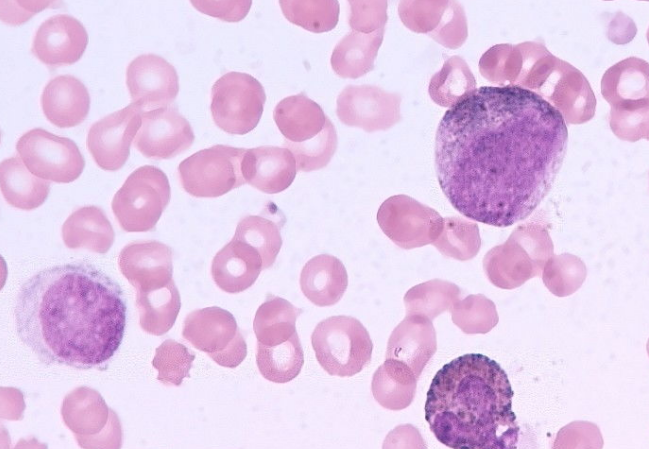

慢性粒细胞白血病引起了人们的极大关注,不仅因为它很危险,还因为它是人类历史上第一种可以被小分子靶向药物有效治疗的癌症。随着药物治疗和检测技术的进步,慢性粒细胞白血病展示了从不治之症到可治疗、可控制甚至可治愈的希望之路。十五年前,虽然造血干细胞移植给病人带来了希望和治愈,但移植受到许多因素的限制,如捐赠者的存在与否和病人的年龄。分子靶向药物酪氨酸激酶抑制剂(TKI)的出现打破了这种有限的疗法。目前,接受连续一线TKI治疗的慢性粒细胞白血病患者的10年生存率已达到85%~90%。
来自欧洲临床研究的数据显示,在接受尼洛替尼一线治疗的慢性髓系白血病患者中,累计56%的患者在6年随访后可获得深度分子缓解(MR4.5),并且MR4.5是进入非治疗性缓解研究的阈值条件。最新的未治疗缓解研究数据显示,超过一半获得持续MR4.5的患者在没有药物治疗的情况下,经过48周的中位随访后仍保持未治疗缓解。
尼洛替尼被批准作为一线适应症,并有望帮助慢性髓系白血病患者实现更早和更深的分子缓解。这将在很大程度上促进慢性粒细胞白血病领域的治疗,甚至使患者希望实现非治疗性缓解,从而减轻经济负担,提高生活质量。尼洛替尼治疗慢性髓系白血病一线适应症的批准是中国慢性粒细胞白血病治疗的又一里程碑,这意味着新诊断的慢性粒细胞白血病患者可以直接接受尼洛替尼,从而更快实现更深层次的分子缓解。此外,欧洲临床研究的进展表明,非治疗性缓解(TFR),即功能性治疗,已成为慢性粒细胞白血病治疗的更高目标。
厄洛替尼药品详细信息请进入:https://www.inmedf.com/zhongliu/bxb/201949.html